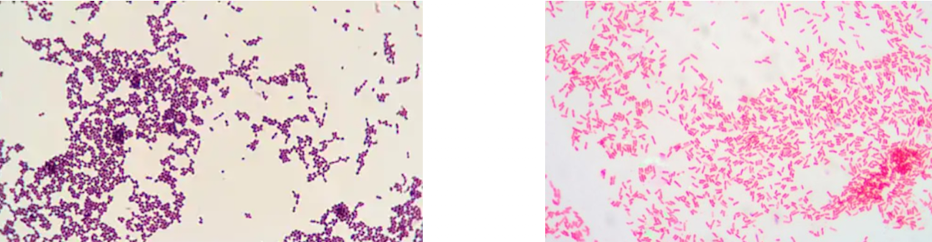

What are the 5 lab tests for infectious agents
- direct stains
- culture
- antigen detection
- nucleic acid amplification
- serology
Which of these is gram positive
The left image is positive
What is this infectious agent

Staph aureus
- gram positive cocci in singles, pairs, clusters
what is this infectious agent

Group A strep pyogenes
- gram positive cocci in long chains
What is this infectious agent

neisseria gonorrhoeae
- gram negative diplococci
What is this infectious agent

Escherichia coli
- gram negative bacilli in urine
What is the gold standard lab for infectious agents
culture
- routine bacteria
- mycobacteria
- fungal infections
What does minimum inhibitory concentration mean
the lowest concentration of antimicrobial agent that inhibits growth of the organism
- sensitive (most inhibition)
- intermediate (some inhibition)
- resistant (no inhibition)
What is the problem with antigen detection testing
cannot distinguish between viable and nonviable organisms (a culture will grow only the live organisms)
Nucleic acid amplification testing can identify…
difficult to grow/slow growing organisms, can use PCR
- HIV viral load
- HSV
- MRSA
- Covid
Serology tests detect…
host antibodies produced in response to infection
What can skin scraping microscopy identify
Fungal infections (KOH prep)
- tinia
- candidiasis
Scabies (mineral oil)
What can a woods light test distinguish
-vitiligo (blue/white)
-hypopigmentation
-tinia capitis (blue/green)
-cutaneous pseudomonas
What does Tzanck testing identify
uses stain to identify herpes simplex or herpes zoster in intact vesicles (cant distinguish between the two)
What can diascopy determine
whether a red lesion is due to blood within a superficial vessel or from hemorrhage


